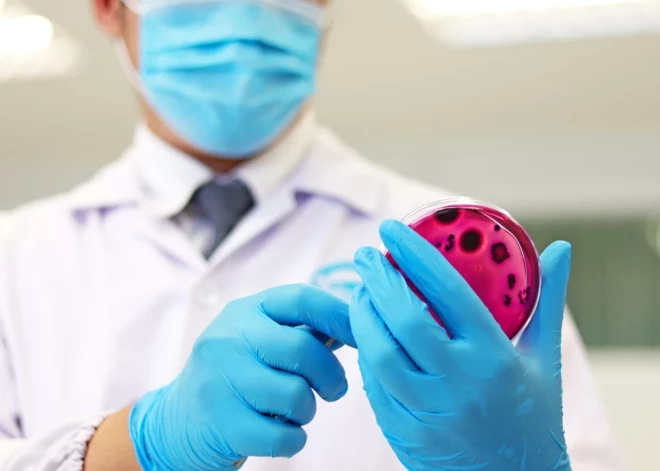

В Латвии выявлены еще три случая опасной инфекции E. coli

В Латвии выявлены еще три случая опасной инфекции E. coli, сообщили агентству LETA в Центре профилактики и контроля заболеваний (SPKC).
SPKC получил три экстренных уведомления о случаях инфекции STEC/VTEC. Все новые случаи заражения зафиксированы у детей, которые были госпитализированы. Два случая подтверждены лабораторно, а один — диагностирован клинически на основании симптомов. Таким образом, в Латвии зафиксировано уже 57 случаев опасной инфекции E. coli.
Как сообщалось ранее, к пятнице случаи заболевания были выявлены в различных районах Риги, а также в Лиепае, Елгаве, Ропажском, Кекавском, Саласпилсском, Адажском, Сигулдском, Цесисском и Южнокурземском краях.
Эпидемиологи ведут расследование случаев по нескольким направлениям и уже предприняты масштабные меры. Предварительные результаты микробиологических исследований указывают на возможные вспышки инфекции E. coli, связанные с отдельными продуктами питания. Также не исключен комбинированный сценарий, когда один и тот же продукт загрязнен несколькими патогенами, добавили в SPKC.
Специалисты Центра продолжают эпидемиологическое расследование источника инфекции.